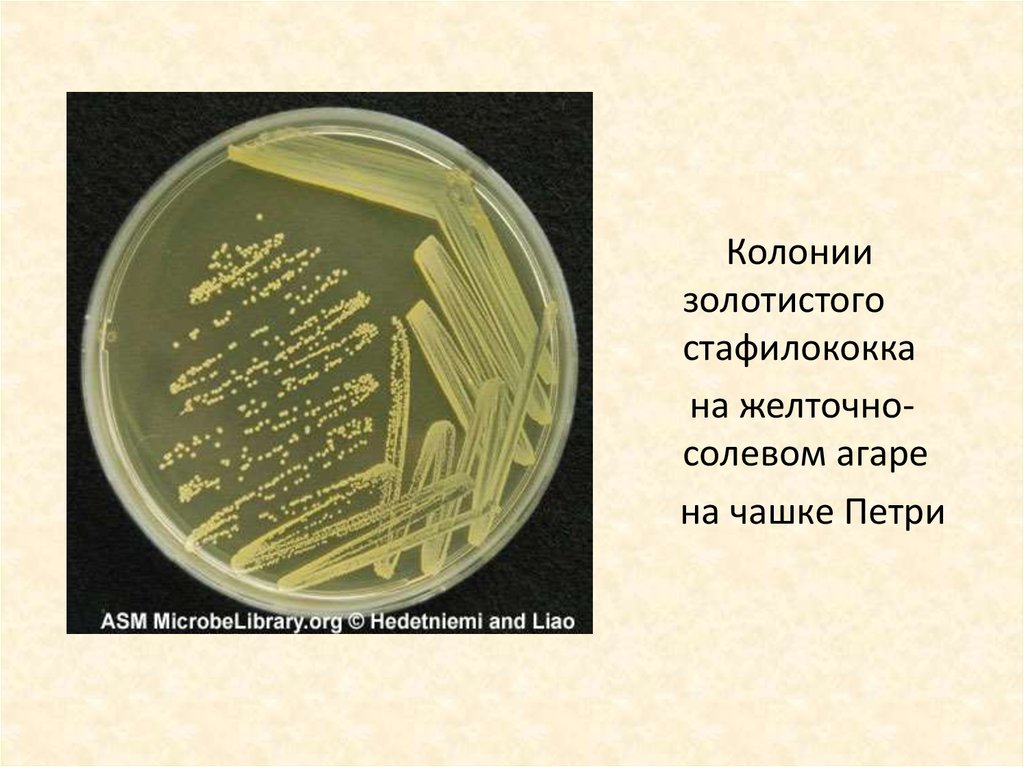

Similar presentations:
Структура бактериальной клетки. Форма бактерий
1.
ОГБОУ СПО «ИВАНОВСКИЙ МЕДИЦИНСКИЙКОЛЛЕДЖ»
Подготовила преподаватель
Симагина Н.Б.
2.
3.
1. Основные клеточные структуры:1. Клеточная стенка
2. Цитоплазматическая мембрана
3. Нуклеоид
4. Цитоплазма
2. Дополнительные клеточные структуры:
1. Жгутики
2. Ворсинки (пили)
3. Рибосомы
4. Капсула
5. Спора
6. Митохондрия
7. Лизосомы
8. Клеточные включения
9. Плазмиды
4. Виды бактерий в зависимости от расположения жгутиков
• Монотрихи• Лофотрихи
• Амфитрихи
• Перитрихи
5.
6. МИКРОКОККИ
Располагаютсяотдельно друг
от друга.
Не патогенны
для человека
7. Диплококки
• Менингококки –возбудители
менингококковой
инфекции.
• Пневмококки –
возбудители
пневмонии.
• Гонококки –
возбудители
гонореи.
8. Менингококковая инфекция
9. Стрептококки
Располагаются цепочками.Вызывают различные
заболевания:
ангину,
• скарлатину,
• ревматизм,
• рожистое воспаление,
• стрептодермию
Особенно опасен
β-гемолитический
стрептококк группы А
10. Стрептококковая ангина и стрептодермия.
11. Рожистое воспаление
12. Стафилококки
Располагаются в видегрозди.
Вызывают такие
заболевания как:
стафилодермии,
фурункулез, абсцесс,
флегмону, мастит,
воспаление пупочной
ранки (омфалит),
сепсис.
Особенно опасен
золотистый
стафилококк.
13.
Колониизолотистого
стафилококка
на желточносолевом агаре
на чашке Петри
14. Абсцесс и стафилодермия
15.
16. Палочковидные бактерии с закругленными концами
Кишечные палочкивызывают различные
кишечные инфекции:
сальмонеллы вызывают
сальмонеллез
Шигеллы вызывают
дизентерию
17. Палочковидные бактерии с заостренными концами
Возбудитель чумы.Окрашивается
интенсивно по
краям, в середине
окрашивание менее
выражено
(биполярное
окрашивание)
18. Бубонная чума
19. Палочковидные бактерии с прямоугольными концами
Возбудительсибирской язвы
располагается
короткими цепочками.
20. Палочковидные бактерии с утолщениями на концах
Данные палочковидныебактерии могут вызывать
заболевания. Например
палочка Лефлера
является возбудителем
дифтерии.
Или могут быть
непатогенными,
например
бифидобактерии
кишечника человека.
21. Извитые бактерии- приспособлены к жизни в воде
Извитые бактерииприспособлены к жизни в воде1. Вибрионы
Представителем
является холерный
вибрион.
Имеет вид «запятой»
с одним жгутиком
22. Обезвоживание IV степени при холере
Малеев В.В., 201123.
2. СпириллыИмеют вид длинных
тонких нитей с
плавными изгибами.
Не патогенны для
человека
24.
3. Спирохетыимеют вид длинных нитей,
напоминающих
«пружинки».
К ним относятся:
1.Трепонемы –
возбудители сифилиса
2. Лептоспиры
возбудители лептоспироза
3. Боррелии – возбудители
возвратного тифа

medicine
medicine








